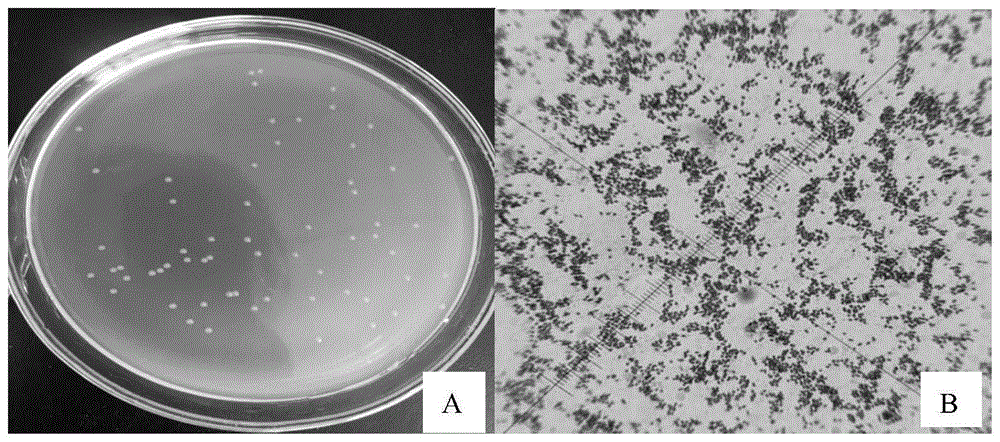
一株假單胞菌及其應(yīng)用

雙五星
一種峰谷電價驅(qū)動的儲能調(diào)峰日前優(yōu)化調(diào)度方法
本發(fā)明是一種峰谷電價驅(qū)動的儲能調(diào)峰日前優(yōu)化調(diào)度方法�,其特點(diǎn)是,包含:充放電區(qū)間優(yōu)先級確立�、儲能調(diào)峰日前優(yōu)化調(diào)度流程、儲能系統(tǒng)在運(yùn)行的過程中需要滿足的約束條件���、儲能系統(tǒng)充放電狀態(tài)約束���、基于粒子群算法的功率優(yōu)化方法、調(diào)度方案評價指標(biāo)等步驟��,通過對儲能系統(tǒng)的充分利用���,從而提高了儲能系統(tǒng)的削峰填谷效果以及其經(jīng)濟(jì)性���。具有方法科學(xué)合理,適用性強(qiáng)�,效果佳等優(yōu)點(diǎn)。
東北電力大學(xué)
授權(quán)發(fā)明